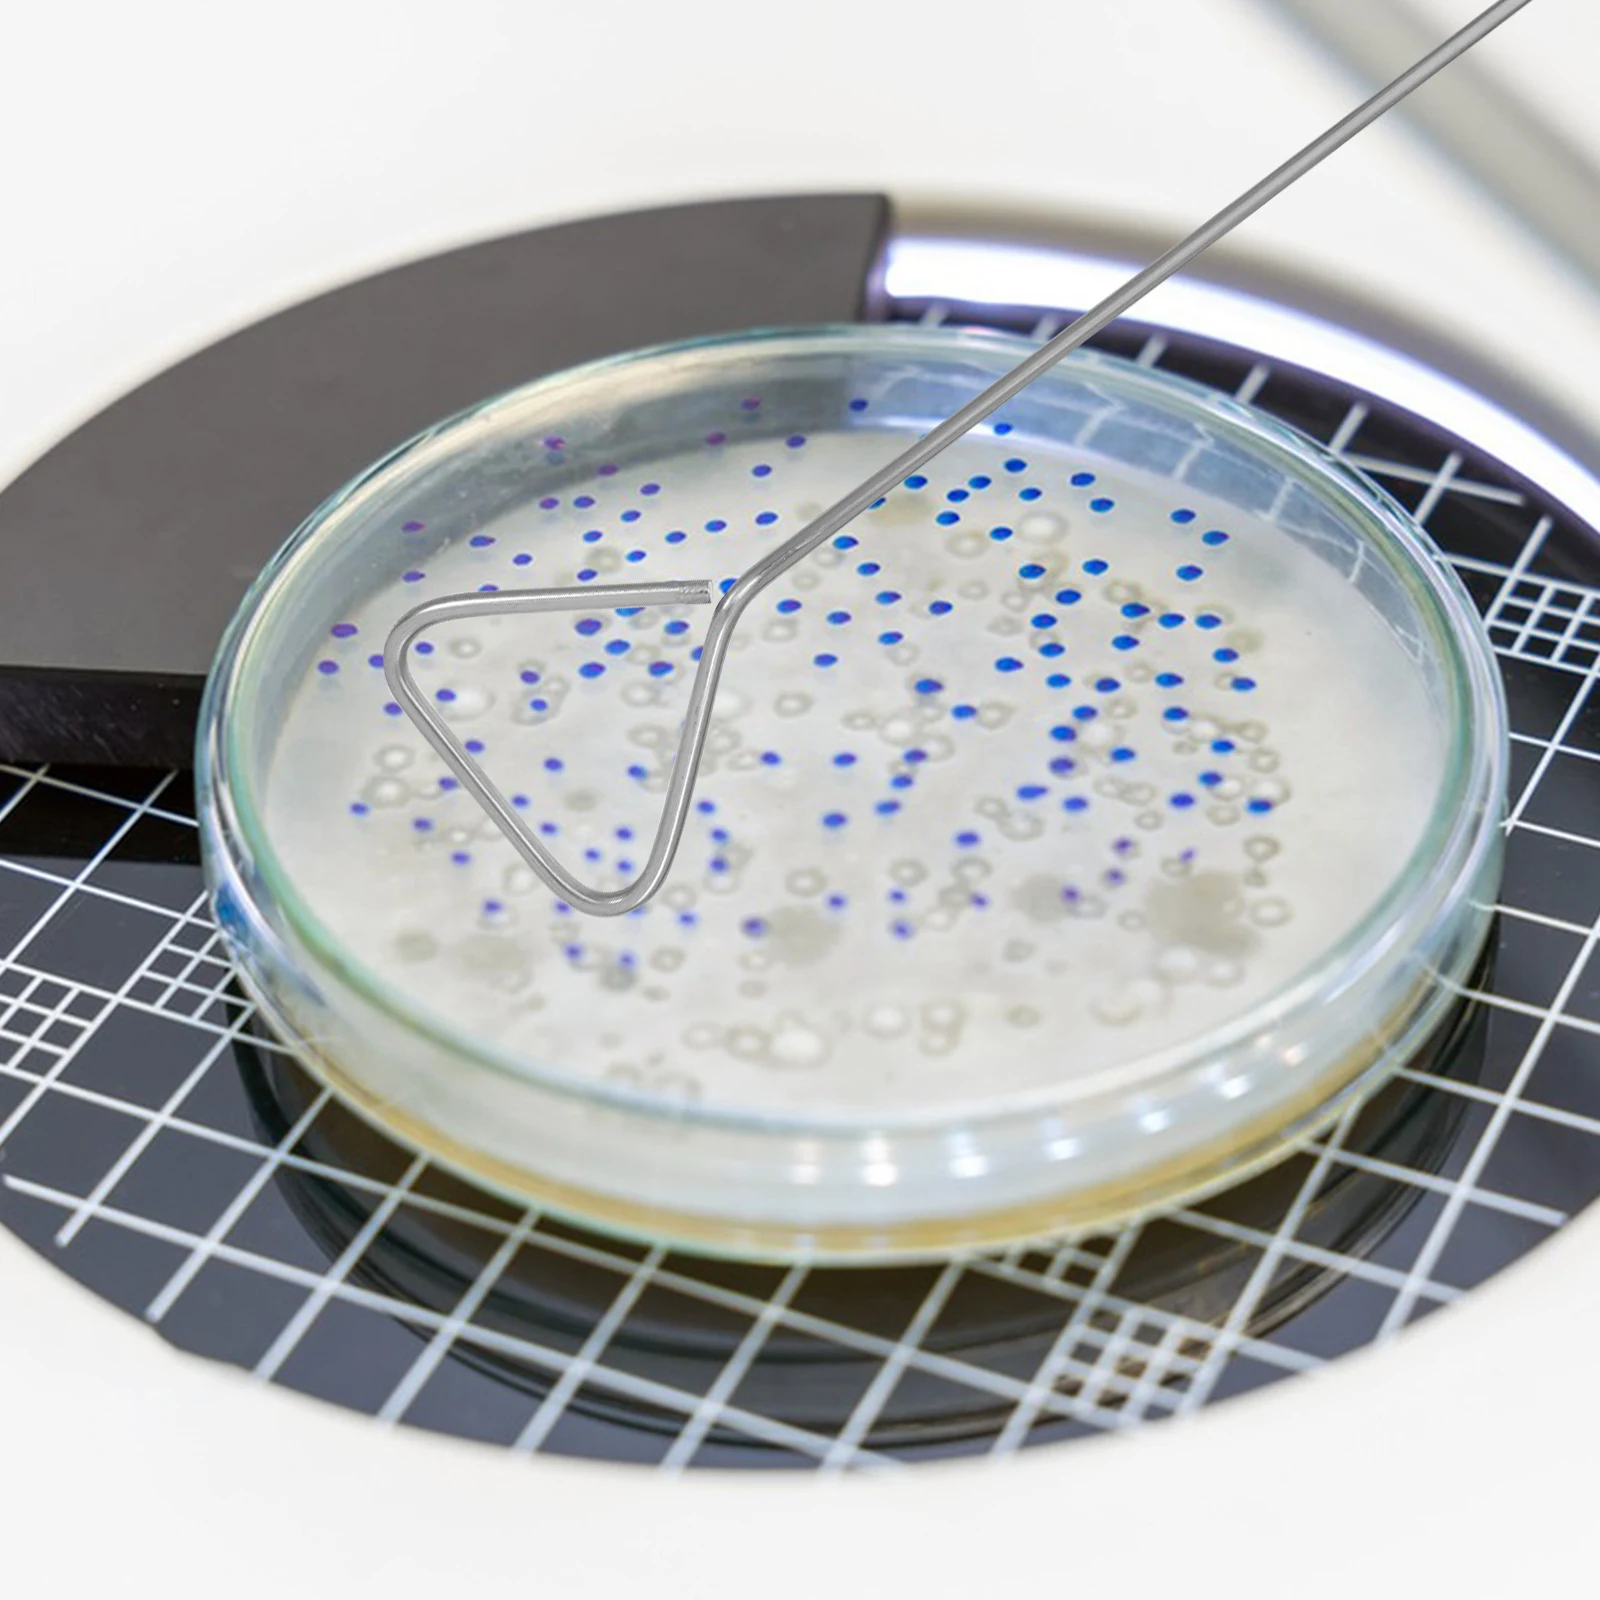
6 Pcs Coating Rod Lab Cell Spreaders Tools and Accessories Stainless Steel Laboratory Ideal for Rigorous Environments

- Home
- Best Sellers
-
All Categories
- All Categories
- Women's Clothing
- Men's Clothing
- Phones & Telecommunications
- Computer & Office
- Consumer Electronics
- Jewelry & Accessories
- Home & Garden
- Luggage & Bags
- Shoes
- Test category 06
- Sports Shoes,Clothing&Accessories
- Weddings & Events
- Beauty & Health
- Office & School Supplies
- Toys & Hobbies
- Industrial & Business
- newlv1categorytest
- Sports & Entertainment
- Mother & Kids
- Watches
- Phones & Telecommunications Accessories
- Motorcycle Equipments & Parts
- Electronic Components & Supplies
- Books & Cultural Merchandise
- Hair Extensions & Wigs
- Lights & Lighting
- Novelty & Special Use
- Home Improvement
- Apparel Accessories
- Underwear
- Security & Protection
- Tools
- Food
- Automobiles, Parts & Accessories
- Home Appliances
- Furniture
- All Stores